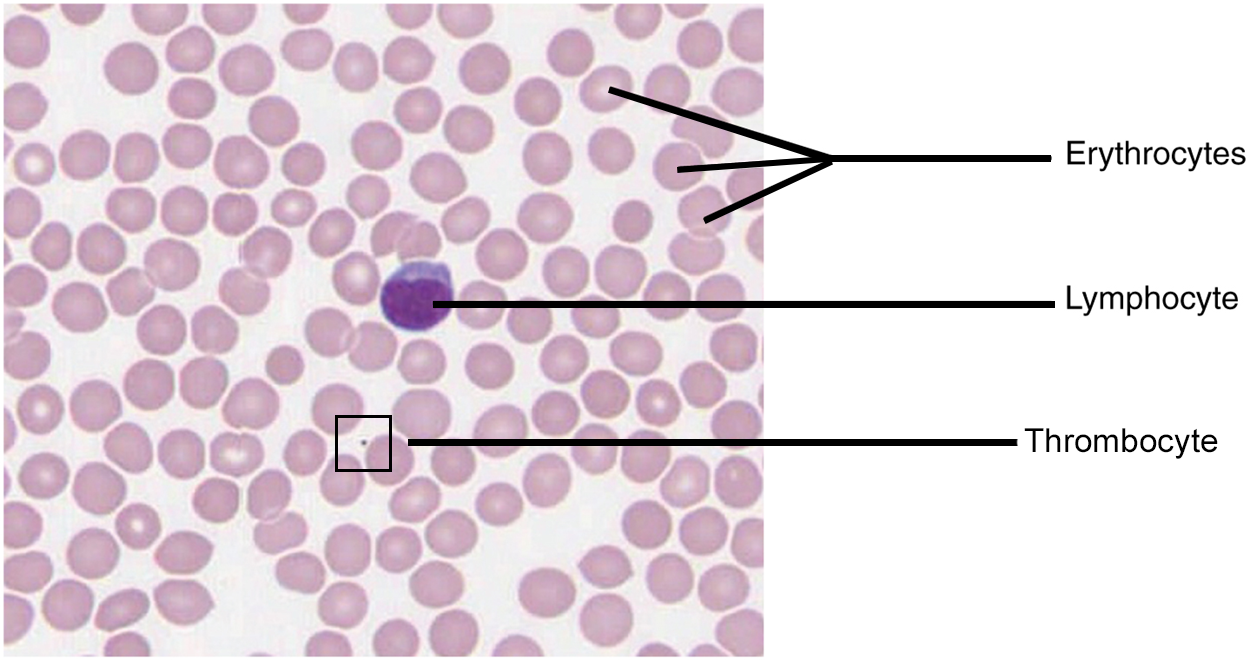
This micrograph of a blood smear shows a group of red blood cells and a single white blood cell. The red cells are small discs that have a slight depression at their centers with no nuclei present. The white blood cell is larger and more darkly stained and has a large, prominent nucleus that is also darkly stained.

Table of Contents |
Welcome to Anatomy & Physiology II, an in-depth exploration of the human body, its components, functions, diseases, and conditions. This course and the adjoining lab course (Anatomy & Physiology II Lab) are follow-ups to the Anatomy & Physiology I courses.
IMPORTANT: Students are strongly recommended to complete Anatomy & Physiology I before starting Anatomy & Physiology II. This course will not review terminology and concepts presented in Anatomy & Physiology I; this course assumes that information was previously learned. The Anatomy and Physiology courses are intended for those looking to work in a healthcare field or with a strong interest in learning about the human body.
In Anatomy & Physiology II (A&P II), you will learn about the cardiovascular, endocrine, lymphatic, respiratory, digestive, urinary, and reproductive systems as well as human development.
After completing this course, you are expected to understand and explain the basic organization of the body, anatomical terminology, how the included organ systems are organized and function to serve the body as a whole, and the foundations of various related diseases and conditions of the included organ systems.
As you progress through this course, there are a few items to keep in mind.
Blood is a tissue, a group of cells that work together to perform a specific function. More specifically, blood is a fluid connective tissue. It is a fluid because it assumes the shape of its container. Recall from A&P I that a connective tissue creates a connection between two or more other tissues. Like all connective tissues, it is made up of cellular elements and an extracellular matrix. The cellular elements, also known collectively as formed elements, include erythrocytes (red blood cells, RBCs), leukocytes (white blood cells, WBCs), and cell fragments called thrombocytes (platelets). The extracellular matrix, called plasma, makes blood unique among connective tissues because it is fluid. This fluid, which is mostly water, perpetually suspends the formed elements and enables them to circulate throughout the body within the cardiovascular system.
The primary function of blood is to deliver nutrients to and remove wastes from body cells, but that is only the beginning of the story. The specific functions of blood also include defense and maintenance of homeostasis such as body temperature, electrolyte levels, and body pH.
Nutrients from the foods you eat are absorbed in the digestive tract. Most of these travel in the bloodstream directly to the liver, where they are processed and released back into the bloodstream for delivery to body cells. Oxygen from the air you breathe diffuses from the lungs into the blood and is transported to the heart, which then pumps it out to the rest of the body. Blood also picks up cellular wastes and byproducts, and transports them to various organs for removal. For instance, blood moves carbon dioxide to the lungs for exhalation from the body, and various waste products are transported to the kidneys and liver for excretion from the body in the form of urine or bile.
Many types of leukocytes (white blood cells, WBCs) protect the body from external threats, such as disease-causing bacteria that have entered the bloodstream in a wound. Others seek out and destroy internal threats, such as cells with mutated DNA that could multiply to become cancerous, or body cells infected with viruses.
When damage to the vessels results in bleeding, thrombocytes (platelets) and certain proteins dissolved in the plasma, the fluid portion of the blood, interact to block the ruptured areas of the blood vessels involved by forming a blood clot. This protects the body from further blood loss.

You have probably had blood drawn from a superficial vein in your arm, which was then sent to a lab for analysis. Some of the most common blood tests—for instance, those measuring lipid or glucose levels in plasma—determine which substances are present within blood and in what quantities. Other blood tests check for the composition of the blood itself, including the quantities and types of formed elements.

As you already learned, blood is composed of formed elements (cells) and plasma (fluid). When blood is drawn from the body, it contains both of these components and is known as whole blood. The formed elements are made up of three types of cells. Erythrocytes, commonly known as red blood cells (RBCs), work to transport oxygen (O₂) to and carbon dioxide (CO₂) away from body cells. Leukocytes, commonly known as white blood cells (WBCs), primarily work to identify and remove potentially harmful or infectious agents from the body. Thrombocytes, commonly known as platelets, are cell fragments that work to clot blood and prevent continued blood loss when a blood vessel is cut or broken open. As you can see in the histology image below, erythrocytes make up the vast majority of formed elements in blood.
After a vial of blood has been drawn, one test that can be performed will determine your hematocrit (also known as packed cell volume, PCV), the percentage of erythrocytes (red blood cells), in a blood sample. It is performed by spinning the blood sample in a specialized centrifuge, a process that causes the heavier elements suspended within the blood sample to separate from the lightweight, liquid plasma. Because the heaviest elements in blood are the erythrocytes, these cells settle at the very bottom of the hematocrit tube. Located above the erythrocytes is a pale, thin layer composed of the remaining formed elements of blood. These are the leukocytes and thrombocytes. This layer is referred to as the buffy coat because of its color; it normally constitutes less than 1% of a blood sample. Above the buffy coat is the blood plasma, normally a pale, straw-colored fluid, which constitutes the remainder of the sample.

A person's hematocrit can vary for a number of reasons including hydration status, elevation (altitude above sea level), recent trauma, disease states, kidney function, and more. When a person becomes dehydrated, their plasma levels decrease which, in turn, increases their hematocrit. This would also be true if the body is producing too many erythrocytes. In reverse, if overhydrated, the plasma levels increase and hematocrit decreases. This would also be true if the number of erythrocytes removed from circulation increased dramatically due to disease or injury.
| Term | Pronunciation | Audio File |
|---|---|---|
| Erythrocyte | eryth·ro·cyte |
|
| Leukocyte | leu·ko·cyte |
|
| Thrombocyte | throm·bo·cyte |
|
| Hematocrit | he·mat·o·crit |
|
When you think about blood, the first characteristic that probably comes to mind is its color. Blood that has just taken up oxygen in the lungs is bright red, and blood that has released oxygen in the tissues is a more dark red. This is because hemoglobin, the protein that allows for erythrocytes to carry oxygen, is a pigment that changes color, depending upon the degree of oxygen saturation.
Blood is viscous and somewhat sticky to the touch. It has a viscosity approximately five times greater than water. Viscosity is a measure of a fluid’s thickness or resistance to flow, and is influenced by the presence of the plasma proteins and formed elements within the blood. The viscosity of blood has a dramatic impact on blood pressure and flow.
EXAMPLE
Consider the difference in flow between water and honey. The more viscous honey would demonstrate a greater resistance to flow than the less viscous water. The same principle applies to blood.Like other fluids in the body, plasma is composed primarily of water: In fact, it is about 92% water. Dissolved or suspended within this water is a mixture of substances, most of which are proteins. There are literally hundreds of substances dissolved or suspended in the plasma, although many of them are found only in very small quantities.
About 7% of the volume of plasma—nearly all that is not water—is made of proteins. These include several plasma proteins (proteins that are unique to the plasma), plus a much smaller number of regulatory proteins, including enzymes and some hormones. The major components of plasma are summarized in the table below. The three major groups of plasma proteins are as follows:
In addition to proteins, plasma contains a wide variety of other substances. These include electrolytes, such as sodium (Na), potassium (K), and calcium (Ca) ions; dissolved gasses, such as oxygen (O₂), carbon dioxide (CO₂), and nitrogen (N₂); various organic nutrients, such as vitamins, lipids, glucose, and amino acids; and metabolic wastes. All of these nonprotein solutes combined contribute approximately 1% to the total volume of plasma.
| Component and % of blood | Subcomponent and % of component | Type and % (where appropriate) | Site of production | Major function(s) |
|---|---|---|---|---|
| Plasma 43–63% | Water 92% | Fluid | Absorbed by intestinal tract or produced by metabolism | Transport medium |
| Plasma proteins 7% | Albumin 54–60% | Liver |
Maintain osmotic concentration. Transport lipid molecules |
|
| Globulins 35–38% | Alpha globulins - liver | Transport, maintain osmotic concentration | ||
| Beta globulins - liver | Transport, maintain osmotic concentration | |||
| Gamma globulins (immunoglobulins) - plasma cells | Immune responses | |||
| Fibrinogen 4–7% | Liver | Blood clotting in hemostasis | ||
| Regulatory proteins <1% | Hormones and enzymes | Various sources | Regulate various body functions | |
| Other solutes 1% | Nutrients, gases, and wastes | Absorbed by intestinal tract, exchanged in respiratory system, or produced by cells | Numerous and varied | |
| Formed elements 37–54% | Erythrocytes 99% | Erythrocytes | Red bone marrow | Transport gases, primarily oxygen and some carbon dioxide |
|
Leukocytes
<1%
Platelets <1% |
Granular leukocytes: neutrophils eosinophils basophils | Red bone marrow | Nonspecific immunity | |
| Agranular leukocytes: lymphocytes monocytes | Lymphocytes: bone marrow and lymphatic tissue | Lymphocytes: specific immunity | ||
| Monocytes: red bone marrow | Monocytes: nonspecific immunity | |||
| Platelets <1% | Megakaryocytes: red bone marrow | Hemostasis |
IN CONTEXT
Career Connection
Phlebotomy and Medical Lab Technology
Phlebotomists are professionals trained to draw blood (phleb-, a blood vessel; -tomy, to cut). When more than a few drops of blood are required, phlebotomists perform a venipuncture, typically of a surface vein in the arm. They perform a capillary stick on a finger, an earlobe, or the heel of an infant when only a small quantity of blood is required. An arterial stick is collected from an artery and used to analyze blood gasses. After collection, the blood may be analyzed by medical laboratories or perhaps used for transfusions, donations, or research. While many allied health professionals practice phlebotomy, the American Society of Phlebotomy Technicians issues certificates to individuals passing a national examination, and some large labs and hospitals hire individuals expressly for their skill in phlebotomy.
Medical or clinical laboratories employ a variety of individuals in technical positions:
- Medical technologists (MT), also known as clinical laboratory technologists (CLT), typically hold a bachelor’s degree and certification from an accredited training program. They perform a wide variety of tests on various body fluids, including blood. The information they provide is essential to the primary care providers in determining a diagnosis and in monitoring the course of a disease and response to treatment.
- Medical laboratory technicians (MLT) typically have an associate’s degree but may perform duties similar to those of an MT.
- Medical laboratory assistants (MLA) spend the majority of their time processing samples and carrying out routine assignments within the lab. Clinical training is required, but a degree may not be essential to obtaining a position.
| Term | Pronunciation | Audio File |
|---|---|---|
| Albumin | al·bu·min |
|
| Globulin | glob·u·lin |
|
| Fibrinogen | fi·brin·o·gen |
|
Source: THIS TUTORIAL HAS BEEN ADAPTED FROM OPENSTAX "ANATOMY AND PHYSIOLOGY 2E" ACCESS FOR FREE AT OPENSTAX.ORG/DETAILS/BOOKS/ANATOMY-AND-PHYSIOLOGY-2E. LICENSE: CREATIVE COMMONS ATTRIBUTION 4.0 INTERNATIONAL